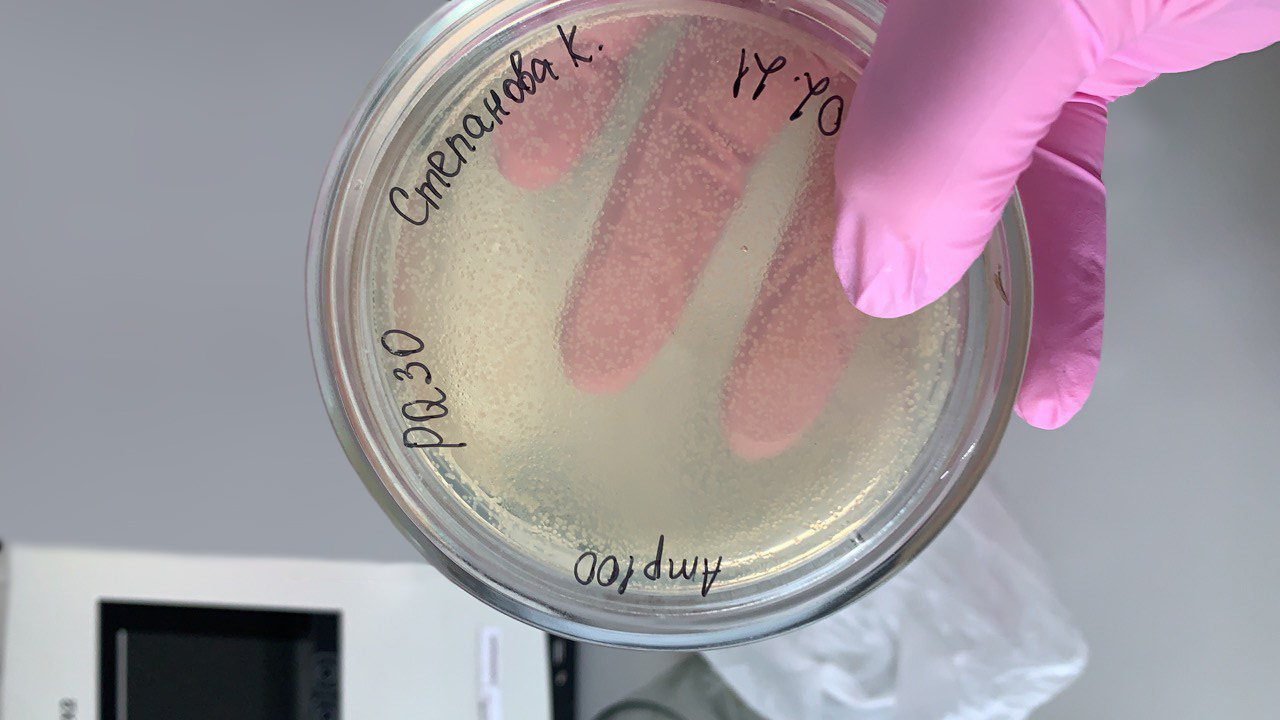
Культивирование бактерий в чашке Петри IMAGE 2021-10-01 09_14_21.jpg

Учёные кафедры генетики и клеточной биологии совместно с кафедрой зоологии беспозвоночных Биологического института Томского госуниверситета исследуют микробиоту клещей – переносчиков возбудителей клещевого энцефалита, боррелиоза (болезнь Лайма) и других инфекций. Исследователи намерены определить микроорганизмы, которые наиболее часто встречаются в кишечнике инфицированных паукообразных. Микробов-симбионтов генетики планируют модифицировать с помощью технологий инженерной биологии и использовать их в качестве инструмента для снижения численности инфицированных клещей.
– Объектами исследования выступают три вида клещей, широко распространённых на территории Сибири и Дальнего Востока: Ixodes persulcatus (таёжный), Ixodes pavlovsky (клещ Павловского) и Dermacentor reticulatus (луговой клещ), – рассказывает старший научный сотрудник лаборатории экологии, генетики и охраны окружающей среды БИ ТГУ Алина Коханенко. – С помощью секвенирования ДНК мы изучаем видовое разнообразие микроорганизмов, обитающих внутри их кишечника, поскольку именно кишечник является местом длительного контакта возбудителя заболеваний и организма клеща.

Задача исследователей – выяснить, какие микроорганизмы чаще всего населяют кишечник клещей, заражённых вирусом клещевого энцефалита либо бактерией-возбудителем болезни Лайма (наиболее распространённых клещевых инфекций). После того как микробы-симбионты будут определены, учёные смогут модифицировать их с помощью технологий геномного редактирования, например, внедрив токсичный агент. При встрече естественной микробиоты клеща с инфекцией будет запускаться механизм выделения токсина в полость кишечника, что приведёт к гибели инфицированной особи.
– Это позволит обеспечить точечное воздействие на популяцию клеща, не ликвидируя её полностью, ведь клещи, потенциально опасные для людей, являются важной составляющей экосистемы. Их существование необходимо для сохранения природного баланса, – говорит Алина Коханенко. – Кроме того, в ходе традиционных противоклещевых обработок местности страдают и другие обитатели экосистемы, помимо клещей. Таким образом, негативное воздействие на окружающую среду будет минимизировано.
Добавим, что наряду с учёными кафедры генетики и клеточной биологии БИ ТГУ в исследованиях задействованы студенты нескольких других кафедр, в том числе новой магистерской программы, запущенной на базе Биологического института. В рамках данной программы магистрантов обучают анализу геномов живых организмов и их редактированию с применением методов биоинформатики и генной инженерии. Эти технологии помогут ответить на глобальные вызовы человечества, бороться с опасными заболеваниями человека и животных, с загрязнением окружающей среды и сохранить видовое разнообразие.
Реализация стратегического проекта ТГУ «Инженерная (синтетическая) биология 2.0: Биопроектирование, молекулярный и клеточный инжиниринг» соответствует целям и задачам Комплексной программы развития биотехнологий, утвержденной правительством РФ. Проект направлен на создание Национального хаба «Инженерная (синтетическая) биология» – сибирского форпоста биотехнологий на базе научных школ экспертного класса. Сотрудничество с научными и бизнес-партнерами (НГУ, институты СО РАН, Сибагро, Фармасинтез, АртЛайф, НОЦ «Кузбасс» и др.) позволит осуществить технологический прорыв в таких направлениях, как «Еда будущего», «Биопрепараты для персонализированной медицины», «Искусственный геном».